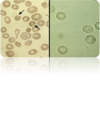

Anemia Flashcards
Etiologies of anemia
- Iron Deficiency 2. Anemia of Chronic Disease (ACD) 3. Thalassemias 4. Sickle Cell Anemia 5. Sideroblastic Anemia 6. Megaloblastic Anemia 7. Primary Bone Marrow Anemia 8 Secondary Anemias 9. Hemolytic Anemia
How do you define anemia
-A reduced number of circulating Red Blood Cells per blood volume from an individual’s baseline value. General Definition: Hgb <12g/dl or Hct < 36% in women Hgb <13.5g/dl or Hct < 41% in men **“Rule of threes” for normal values: RBC = 5.0 x106/uL, Hb = 15 g/dL, Hct = 45%
What values are important on a CBC
- Hgb 2. Hct 3. Reticulocytes 4. MCV– how big (morphologic approach) 5. MCH 6. RDW (RB volume distribution width percentage)
__ count are all dependent on RBC Mass (RCM) as well as Plasma volume
Hgb, Hct, and RBC *so therefore values will be decreased if RCM is decreased or Plasma Volume is increased
Patients who are volume depleted (e.g. acute post-hematemesis) may show normal ___ an underlying anemia may be unmasked when volume is repleted
Hgb / Hct,
In the 3rd trimester of pregnancy ___ are expanded by 25 and 50% respectively, resulting in ___.
RBC Mass and Plasma Volume Hgb/Hct reductions *You may hear the term “physiologic” or “dilutional” anemia applied in this case.
What are special populations that can alter someones Hgb, Hct?
- high altitude– higher than sea level 2. smokers- May have higher than normal Hct, occasionally approaching polycythemic levels. 3. AA- lower Hgb 4. international population– malnutrition, infection, congenital heme disorders 5. athletes
Erythropoiesis in the adult takes place in the ___ under the influence of the stromal network, cytokines, and erythropoietin (EPO).
bone marrow
In anemia there is a Prolongation of ___ maturation time
reticulocyte
strenuous sports or the use of performance enhancing agents (such as EPO or androgens) have been known to cause a dilutional anemia secondary to an increased __, ___, ___, ___ as well as ___ have all been reported
plasma volume, GI Bleeding, intravascular hemolysis, iron deficiency as well as polycythemia
A normal bone marrow replete with __, __, and __ can increase erythropoiesis in response to EPO approximately fivefold in adults and seven- to eightfold in children.
iron, folate, and cobalamin
The resulting mature RBC circulates for __ days, after which it is removed from the circulation by macrophages that detect senescent signals, primarily on the RBC membrane, through mechanisms that are poorly understood.
110 to 120 days
Approximately ___ red blood cells are produced per hour in the bone marrow to maintain the hemoglobin level within fairly narrow limits.
10^10 (ten billion)
Symptoms from anemia can result from two factors:
(1) decreased oxygen delivery to tissues, and, in patients with acute and marked bleeding, the added insult of (2) hypovolemia.
Describe what happens with total blood volume in anemia
total blood volume remains normal in anemia due to chronic, low-grade bleeding, since there is plenty of time for equilibration within the extravascular space and renal retention of salt and water.
How do tissues compensate for decrease oxygen delivery to tissues in anemia
- Increased SV 2. HR (therefore cardiac output) and 3. increased extraction of oxygen by the tissues .
Primary symptoms of anemia
- exertional dyspnea 2. dyspnea at rest 3. varying degrees of fatigue** 4. signs and sx of hyperdynamic state (bounding pulses, palpitations, postural hypotension, roaring in the ears) 5. more severe: lethargy and confusion **Tend to be vague and non-specific
PE findings of anemia
*Physical exam findings are poorly sensitive and specific with wide inter-observer differences. 1. pallor (face, nailbeds, conjunctiva, palms) 2. jaundice 3. Petechiae or bruising 4. LAN/HSM/sternal tenderness= concern for bone CA 5. tachy, dyspnea, fever, hypotension, *Stool should always be assessed for occult blood
According to the kinetic approach, the following three questions are asked in order to determine the mechanism(s) causing the anemia.
- Is there evidence for decreased red cell production? 2. Is there evidence for increased red cell destruction (hemolysis)? –> jaundice 3. Is there a history of bleeding? (bright red blood in stool, mensturation, dark stools)
Iron Deficiency Anemia (IDA) in the US is almost always secondary to ___
blood loss.
types of hemorrhagic anemia (blood loss)
- Obvious Bleeding (e.g. trauma, melena, hematemesis, or menometorrhagia) 2. Occult Bleeding (e.g. Slow bleeding ulcer or carcinoma) Induced bleeding (e.g. 3. Hemodialysis, excessive donation, iatrogenic post surgical)
What happens in hemolytic anemia
In hemolytic Anemia (Increased RBC Destruction), bone marrow is unable to keep up with the need to replace more than about 5% RBC Mass per day.
Factors of hemolytic anemia
- Erythrocyte factors (memrane, surface protein, enzyme deficit, hemoglobinopathies) -inherited (sickle cell, thalassemia, spherocytosis) 2. Plasma Factors: -Ab, drug induced -autoimmune hemolytic anemia, thrombotic thrombocytopenic purpura, HUS 3. Mechanical heart valve 4. burns
What are causes of decreased RBC production
- Nutritional: Lack of nutrients, such as iron, B12, folate. (dietary lack, malabsorption, or blood loss) 2. Marrow infiltration 3. bone marrow suppression 4. Low levels of Trophic Hormones which stimulate RBC Production: e.g. EPO (chronic renal failure), Thyroid (hypothyroidism), and androgens 5. Anemia of Chronic Disease / Infection – infectious, inflammatory, malignant disorders